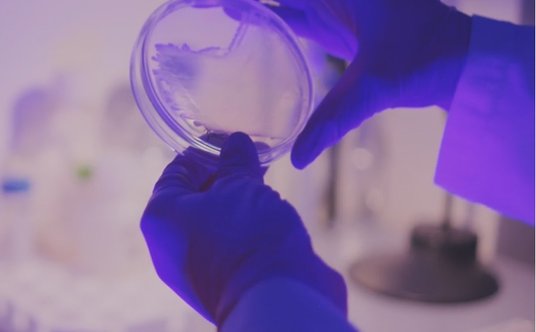
Badania w toku: Szalka Petriego w dłoniach naukowca

Medycyna spersonalizowana, choroby nowotworowe i genetyczne – nauka we wsparciu diagnostyki i terapii: W Środowiskowej Pracowni Spektrometrii Mas (mslab-ibb.pl) kierowanej przez prof. Michała Dadleza, prowadzone są badania nad biomarkerami chorób oraz opracowywane panele diagnostyczne, m.in. dla endometriozy. Zespół, we współpracy z sektorami medycznym i BioTech, identyfikuje i optymalizuje biomarkery, które w przyszłości mogą zostać wdrożone w diagnostyce pacjentów. W pracowniach naukowych IBB PAN (m.in. prof. Róży Kucharczyk i prof. Tomasza Sarnowskiego) wykorzystywane są molekularne modele ludzkich chorób (w tym genetycznych) wprowadzane do drożdży, nicieni i roślin, co daje możliwość rozwoju spersonalizowanych terapii (medycyna translacyjna). Badania dr hab. Beaty Burzyńskiej wspomagają decyzje terapeutyczne podejmowane przez lekarzy, umożliwiając ocenę patogenności zmian genetycznych (VUS). Badania nad RNA (m.in. dr hab. Tomasz Turowski) oraz nanociałami (prof. Tomasz Sarnowski) otwierają nowe możliwości leczenia chorób nowotworowych, i genetycznych, także chorób rzadkich. Od 2018 roku IBB PAN organizuje konferencje z okazji Dnia Chorób Rzadkich (chorobyrzadkie.ibb.edu.pl), umożliwiając wymianę wiedzy i doświadczeń między naukowcami, lekarzami i pacjentami. Z kolei zespoły dr hab. Tamary Aleksandrzak-Piekarczyk i dr hab. Magdaleny Kowalczyk badają potencjał bakterii kwasu mlekowego w terapii nowotworów i chorób neurologicznych, co wpłynie na rozwój nowych metod wspomagania leczenia opartych na probiotykach.
Bioinformatyka w projektowaniu leków: W Zakładzie Bioinformatyki pod kierownictwem prof. Piotra Zielenkiewicza od lat rozwijane są komputerowe metody projektowania leków, wspierające terapię chorób cywilizacyjnych. Kluczowym obszarem badań są oddziaływania białko–białko, które odgrywają istotną rolę w procesach biologicznych. Ich zaburzenia mogą prowadzić do nowotworów, chorób neurodegeneracyjnych oraz mogą wpływać na przebieg infekcji wirusowych i bakteryjnych. W zakładzie opracowano innowacyjne metody komputerowego projektowania inhibitorów tych interakcji, wykorzystując sztuczną inteligencję. Opracowane rozwiązania mają potencjalne zastosowanie w leczeniu mukowiscydozy, nowotworów i infekcji lekoopornych. Część z nich objęto ochroną patentową.
Badania w toku: Szalka Petriego w dłoniach naukowca
Zwalczanie infekcji – innowacyjne strategie walki z drobnoustrojami: Zespół dr hab. Tamary Aleksandrzak-Piekarczyk bada bakteriocyny – małe białka zdolne do niszczenia drobnoustrojów chorobotwórczych poprzez degradację ich błony lub ściany komórkowej. W zespole prof. Małgorzaty Łobockiej analizowane są bakteriofagi, czyli wirusy atakujące wyłącznie bakterie, w tym gronkowca złocistego, co może stanowić alternatywę dla antybiotyków w walce z lekoopornymi szczepami. Zespół prof. Wojciecha Bala opracował natomiast żel o właściwościach bakterio- i wirusobójczych, który można powierzchniowo aplikować na materiały codziennego użytku.
Drobnoustroje w biotechnologii – innowacyjne zastosowania: W kontekście Europejskiego Zielonego Ładu kluczowe znaczenie ma zrównoważone gospodarowanie zasobami, w tym przetwarzanie bioodpadów i produktów ubocznych przemysłu spożywczego na czystą energię i surowce. Przykładem skutecznej biotechnologii jest modernizacja oczyszczalni ścieków w Cukrowni Dobrzelin (KGS SA) przy udziale dr hab. Anny Sikory. Z kolei zespół prof. Joanny Kruszewskiej rozwija technologie wykorzystujące grzyby do osuszania i utylizacji odpadów oraz redukcji emisji odorów. Pracuje też nad mikroorganizmami o zwiększonych właściwościach biokontrolnych, zdolnymi do wydzielania enzymów hydrolitycznych.
Preparaty biotechnologiczne pochodzenia roślinnego: IBB PAN jest ośrodkiem referencyjnym w badaniach nad poliizoprenoidami. Zespół prof. Ewy Kuli-Świeżewskiej stworzył Collection of Polyprenols – unikalną w skali międzynarodowej kolekcję preparatów izoprenoidowych. Są one dostępne dla laboratoriów badawczych i biotechnologicznych w ramach współpracy naukowej lub na zasadach komercyjnych (bezpośrednio lub www.larodan.com). Izoprenoidy znajdują zastosowanie jako substraty do badania szlaków metabolicznych oraz standardy w analizie składu lipidowego tkanek, także w kontekście stanów patologicznych. Ich kationowe pochodne mogą być stosowane jako nośniki w szczepionkach oraz farmaceutykach, poprawiając skuteczność i sposób podawania leków.
Od badań do wdrożeń: Każde odkrycie przybliża nas do lepszej przyszłości, o ile zostanie wdrożone w praktyce. Mając świadomość znaczenia przełożenia wyników badań na realne zastosowania, IBB PAN aktywnie wspiera transfer technologii do przemysłu i medycyny. Zapraszamy do współpracy!
Materiał Partnera
























